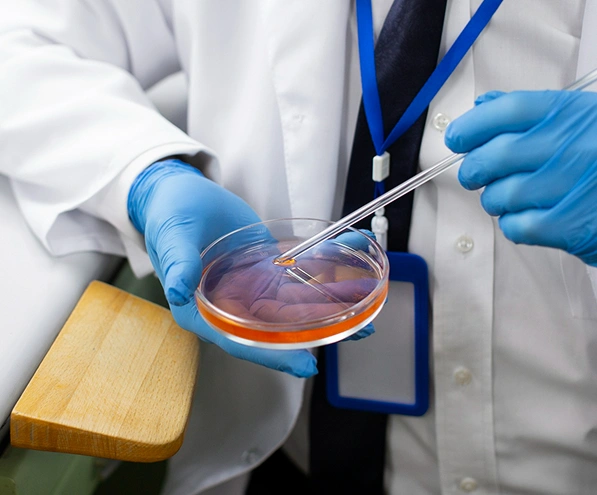
about-image

SAR HEALTHLINE is a prominent provider of products for Assisted Reproductive Techniques (ART). We offer the reproductive medical community a single, comprehensive source for high-quality ART products.
SAR is dedicated to advancing reproductive medicine by supplying innovative products and providing excellent customer service through our nationwide distribution network.

SAR HEALTHLINE is a prominent provider of products for Assisted Reproductive Techniques (ART). We offer the reproductive medical community a single, comprehensive source for high-quality ART products.
SAR is dedicated to advancing reproductive medicine by supplying innovative products and providing excellent customer service through our nationwide distribution network.
















Mauris rutrum cursus mollis. Integer rutrum vel purus ac malesuada. Etiam bibendum a tellus sit amet volutpat.
Our Blogs





I'd received a topnotch service from SAR Health, the provided admonition and results every interval of time. Holding that kind of perception into my life is invaluable.

SAR Health line is one stop shop for every consumable and media requirements. Absolutely good service; no hassles in billing and handles even urgent requirements of media. Products are very good and useful.

Thank you for arranging party for embryologists on 'World Embryologist day' on short notice. The arrangements were excellent. Once again thank you to SAR and your team for helping us.

Thank you for your wholehearted support. We enjoyed a lot on this special day. And also, thanks for your surprise gift. Willing for same support and response always

The Embryology Day gathering at Four point Sheraton was excellent. The management in the form of arrangement, music, food and ambience was remarkable. Thanks again.

Thnq sooo much for inviting us??Gift is awesome. All Arrangements, venue, dinner, cake, specially was just up to the mark.We had enjoyed a lot. Once again Thank you so much for making our day one of the most memorable day??


